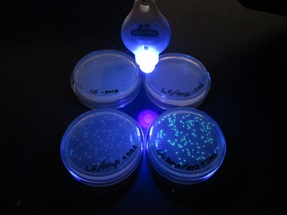

![]() |
![]() |
SSR:台湾海外研修
3月8日(日)~3月15日(日)
台湾での体験を通して、将来の進路や社会での活躍に向けて広い視野と実践的な力を養うことを目的とし、海外研修を実施しました。
台南市の現地校との合同授業・交流活動、ホームステイによる現地学生との家庭生活体験、成功大学でのPBL(課題解決型学習)形式のワークショップ、歴史・文化施設の見学などの活動を通して、異なる文化を理解するとともに、自分で課題を見つけて考える力を養いました。
![]() |
![]() |
SSR:天文学実習@東京大学
2月21日(土)~2月22(日)
東京大学大学院理学系研究科宇宙惑星科学機構の三戸洋之特任研究員の協力のもと、天体観測の講義と実習、プレゼンテーションを行い、科学や研究への興味と関心を高めました。
実習ではいくつかの銀河の距離を求め、その後退速度から宇宙年齢を求めるという壮大な課題にチャレンジしました。
数人の班で協働的に方法や数値の扱い等の議論を重ね、思考を深め、自分なりの結論を出して発表することで、コミュニケーション能力を養うとともに、進路についても考える機会となりました。
![]() |
![]() |
SSR:つくばサイエンスツアー
12月20日(土),21日(日)
筑波研究学園都市において、自然科学や科学技術に関する最先端の施設と展示物を見学、体験するとともに、学校で体験できない科学の世界に触れ、自然科学と技術および知識基盤社会への興味と関心を高めるとともに、自身の進路についても考える機会としています。
全校生徒希望者対象で、この分野に興味のある40名の生徒が参加しました。
JAXA筑波宇宙センター、KEK(高エネルギー加速器研究機構)、地図と測量の科学館(国土地理院)、筑波実験植物園(国立科学博物館)、地質標本館(産業技術総合研究所)、つくばエキスポセンターと多くの施設を訪れ、有意義な研修となりました。
◆生徒の感想◆
・科学は教科書の中で完結するものではなく、社会や私たちの生活と強く結びついた「使われる知識」であることを実感した。
・実際に足を運ぶことで、調べるだけでは得られない感動や楽しさがあると感じた。
・自分が何に興味があるのか理解し直すきっかけになり、進路を考えるにあたってとてもいい経験になった。
![]() |
![]() |
SSR:つくばサイエンスツアー~事前研修~
12月19日(金)
つくばサイエンスツアーの実施前に本校物理科教諭による事前研修を行いました。
参加動機を踏まえて、2日間の研修テーマを設定し、研修施設の館内図・展示内容を調べて、当日の研修計画案を作成しました。
また研修後に、「事前研修と現地の研修を通して新たに知ったこと、分かったこと」「研修を終えて持つに至った考え、自身の変化、成長したこと、今後実践すること」をまとめて提出するよう課題が出されました。
![]() |
![]() |
SSR:生命科学セミナーⅠ~DNA鑑定・科学捜査入門~
12月14日(日)
瑞浪市にあるサイエンスワールドにて、職員の方のご指導のもと、自分の口腔内の表皮細胞を用いた遺伝子配列の分析や、DNA型鑑定をもとにした科学捜査の手法の実験を行いました。
全校生徒希望者対象で、この分野に興味のある23名の生徒が参加しました。
生命科学分野での先端科学実験を体験することによって、遺伝子と遺伝子工学の可能性について考え、また実験での基本的手法を学ぶことを目的としています。
◆生徒の感想◆
・普段できないような実験を丁寧にできて、とても楽しかったし面白かった。実際に使われている技術がより身近になる良い経験となった。
・特捜班になったつもりで楽しめた。自分のDNAを調べることなんて滅多にない経験で面白かった。将来仕事としてこういうことをやってみるのも面白いかもしれないと思った。
・DNAについては生物の授業でも習ったが、このセミナーを通してより理解が深まった。
![]() |
![]() |
SSR:生命科学セミナーⅠ~プレレクチャー~
12月12日(金)
生命科学セミナーⅠの実施前に本校生物科教諭による事前講義を行いました。
DNAやバイオテクノロジーに関する知識を確認、整理しました。当日使用する実験器具を実際に使ってみることで、使用方法や注意点を理解しました。
![]() |
![]() |
SSR:地学講座Ⅰ~火山学~
12月11日(木)
信州大学理学部教授の齋藤武士先生による地学講座「火山学」を実施しました。
「火山噴火と災害」というテーマで、火山の種類とつくられる仕組みの違いや地球の内部構造、日本における火山活動や噴火による災害と防災について、分かりやすくお話しくださいました。
講義終了後には先生に個別で質問をする姿も見られました。
対面で大学の先生の講義を受けることができる貴重な時間となりました。
![]() |
![]() |
SSR:生命科学セミナーⅡ~光る大腸菌~
12月9日(火)~12日(金)
SSH事業の一環として生物基礎の授業で本校生物科教諭による「光る大腸菌」の実験を実施しました。
大腸菌の遺伝子組換えを行い、紫外線で光る大腸菌をつくりました。
遺伝子組換え操作を通して、生命科学分野での先端科学技術を体験し、学習意欲の向上を図り、遺伝子と遺伝子工学の可能性について考え、研究・実験の基本的手法を学ぶ機会としました。
![]() |
![]() |
課研・総合探究:SSH研究発表交流会~普通科の部~
11月6日(木)
2年次生普通科の生徒が企画・運営・発表する総合探究発表会を行いました。
2年次生全クラスと1年次生普通科の生徒が12会場に分かれ5~6名(内2名が発表者)のグループを作り、発表5分+意見交流5分の計10分を、前半2サイクル+後半2サイクルの形式で行いました。
意見交流会では、グループ内でまずテーマ・仮説・アンケート結果・考察の中から良かった点について、次に質問や提案について意見をもらいました。
![]() |
![]() |
課研・総合探究:SSH研究発表交流会~理数科の部 見学~
11月5日(水)
2年次生理数科の生徒が企画・運営・発表する課題研究発表会を見学しました。
第1部は1,2年次生普通科の生徒が、物理・化学・生物の代表班によるステージ発表を見学しました。
第2部は2年次生普通科の生徒が、各教室で行われるブース発表や、各実験室に展示されている実験器具やリサーチノート等を見学しました。
![]() |
![]() |
SSR:科学の甲子園 岐阜県大会
11月1日(土)
科学の甲子園 岐阜県大会(岐阜県教育委員会主催)が岐阜県総合教育センターにて開催され、本校から1年生チームが出場しました。午前は筆記競技、午後は「『ハンドパワー』で伝えて運べ!~空気圧マジックハンドと触覚情報伝達~」というテーマの実技競技に、協働的に取り組みました。
![]() |
![]() |
SSR:サイエンスパーク
10月25日(土)
中学生対象の科学探究塾を開催しました。
第1部はサイエンスワールドの講師の方による実験講座、第2部は参加した中学生を中心とした研究発表交流会を行いました。
科学部の生徒がTAとして参加し、第1部では実験の指導やサポートを、第2部では自身の研究発表や中学生の研究発表に対する質問やアドバイスをし、後輩へのアドバイザーとして活躍しました。
![]() |
![]() |
SSR:えなしこどもフェスタ2025
7月26日(土),27日(日)
恵那文化センターで「えなしこどもフェスタ」が開催され、サイエンススタッフとして教育系を目指す生徒や科学部の生徒が参加しました。
「回転のぞき絵」のブースを出展し、子どもたちに科学をつかった工作の指導をしました。
![]() |
![]() |
総合探究:サマーセミナー
7月24日(木),25日(金)
普通科1年次生の生徒が長野県で1泊2日の宿泊研修を実施しました。
「地域の課題を解決しよう」の一環として他の市町村の取り組みを実地検証し、探究の基礎を学ぶとともに地域課題の解決方法を見つけ出す一助とします。また大学と連携し講義を受けることで、学術分野の学びについて触れる機会とします。
1日目は公立諏訪東京理科大で大学の出前授業と茅野市役所の方による出前講座を受講し、茅野市八ヶ岳総合博物館の見学と学芸員の方による講話を聞きました。
2日目は岡谷蚕糸博物館シルクファクトおかやと北澤美術館の見学と学芸員の方による講話、エプソンミュージアム諏訪ものづくり歴史館を見学し、諏訪市公民館においてグループワークを行いました。
![]() |
![]() |
総合探究:探究基礎講座~物理~
4月24日(木),5月1日(木),5月8日(木)
「総合的な探究の時間」に普通科1年次生を対象にした探究基礎講座を実施しました。物理・化学・生物の各分野において1週ごとに実験を行い、実験を通して探究のプロセスを学びました。
物理では「紙コップの不思議」を行いました。仮説を立てて実験し、得られた結果から考察を行う流れを繰り返し、レポートにまとめます。レポートにはテーマ:Title、目的:Purpose、仮説:Hypothesis、実験方法・使用器具:Experimental Design、結果:Results、考察・結論:Conclusion、活動の振り返り:Future Directionsの項目立てをし、評価ルーブリックによって一項目ごとに評価する手法までを身に付けます。
![]() |
![]() |
総合探究:探究基礎講座~化学~
4月24日(木),5月1日(木),5月8日(木)
化学では「科学のものの見方・捉え方を身に付けること」を目的とし、実験「銅元素の保存」を行いました。
仮説を立ててから実験を行い、現象をよく観察し、実験結果からその現象がなぜ起こるのか考えます。考えられる要因を挙げ、どの要因が強く影響するのか検証するための実験プランを班ごとに考え、発表し合います。その後、代表的な検証実験を行ってレポートにまとめます。
![]() |
![]() |
総合探究:探究基礎講座~生物~
4月24日(木),5月1日(木),5月8日(木)
生物では「ミクロの世界を見てみよう 顕微鏡の使い方」を行いました。
日常的に目にしているものをミクロの視点で見ることで、普段は何気なく見過ごしている生物や物質の不思議を実感することを目的としました。この実験を通して、日常生活や自然から問いを生み出す習慣を身に付けるとともに、視点を変えることによってものの見え方が変わってくるという気付きを得ることを学びます。